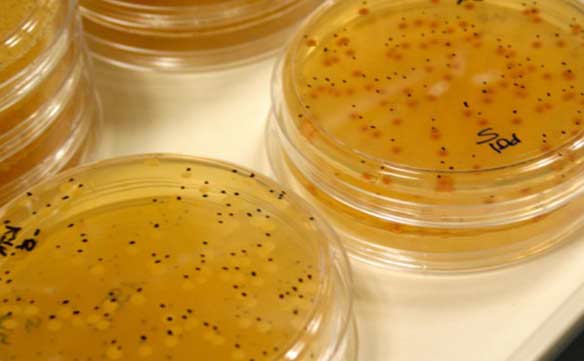
casardeburbia_bodega_mosto

DECÁLOGO DE VITICULTURA
1
No uso de herbicidas y sistémicos.
2
Manejo racional del suelo, evitando la erosión y desertización de los
suelos altos.
Partes altas: hierbas hasta la altura de los racimos y siega en agosto
para mejor maduración de la uva.
Partes bajas: siega desde el inicio de vegetación
3
Abonado racional con materia orgánica, en función de análisis de los
microorganismos del mismo
4
Tratamientos con infusiones de Salvia, cola de caballo
5
Manejo de la vegetación de forma manual: Poda en verde, deshojado
manual, etc.
6
Conversión varietal del palomino a la Mencia con técnicas tradicionales
de Injerto,
como injerto de meseta y pua que nos permite mantener la raíz antigua
con producción más escasa y por tanto de más calidad.